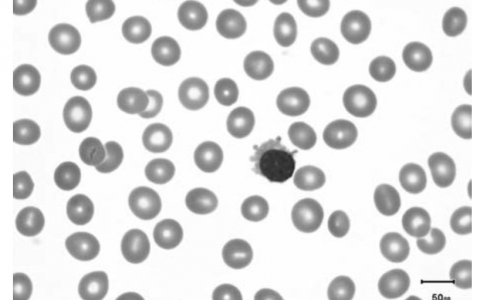
每日一题_2023.01.14

A 53-year-old woman presents with irregular menstrual periods. She claims that she some- times goes two-three months without a period. On further questioning, she also complains of vaginal dryness and occasional hot flashes. Blood tests reveal an estrogen level of 22 pg/mL (normal: 60-400 pg/mL), follicle-stimulating hormone (FSH) level of 100 mIU/L (normal: 1-26 mIU/L), and luteinizing hormone level of 50 mIU/mL (normal: 1-12 mIU/L), without surge. Which of the following is most likely the primary cause of this patient’s symptoms?
一名 53 岁的女性因月经不调就诊。 她声称自己有时会两到三个月没有月经。 进一步询问时,她还抱怨阴道干燥和偶尔出现潮热。 验血显示雌激素水平为 22 pg/mL(正常:60-400 pg/mL),促卵泡激素 (FSH) 水平为 100 mIU/L(正常:1-26 mIU/L),黄体生成素水平 50 mIU/mL(正常:1-12 mIU/L),无激增。 以下哪项最有可能是该患者症状的主要原因?
(A) Decreased estrogen levels雌激素水平降低
(B) Decreased feedback on the anterior pituitary 垂体前叶的反馈减少
(C) Increased FSH levelsFSH 水平升高
(D) Increased progesterone levels 孕激素水平升高
(E) Increased testosterone levels 睾酮水平升高
答案解析:
更年期是由于卵巢功能障碍和可用卵泡数量减少导致卵巢对促性腺激素刺激的敏感性丧失而导致雌激素停止产生。 在美国,绝经的平均年龄为 51 岁,正常范围为 45-55 岁。 请记住,更年期会导致严重后果:潮热、阴道萎缩、骨质疏松症和冠状动脉疾病 (CAD)。 雌激素是维持和发展阴道和骨沉积所必需的,因此减少会导致阴道萎缩和骨质疏松症。 雌激素与心脏病之间没有直接联系,但绝经后 CAD 的发病率比绝经前妇女高两到三倍,这表明内源性雌激素具有一定的保护作用。 潮热与下丘脑识别体温的能力变化有关。 由于雌激素替代疗法可缓解这些症状,因此雌激素可能在体温调节中发挥作用。 该患者的雌激素水平较低 (<100 pg/ml),促卵泡激素 (FSH) 和黄体生成素 (LH) 水平升高。 由于雌激素的反馈抑制减少,绝经期 FSH 和 LH 水平升高,但这些水平并不是绝经的主要原因。
正确答案:A
原创文章(本站视频密码:66668888),作者:xujunzju,如若转载,请注明出处:https://zyicu.cn/?p=15084

 微信扫一扫
微信扫一扫  支付宝扫一扫
支付宝扫一扫